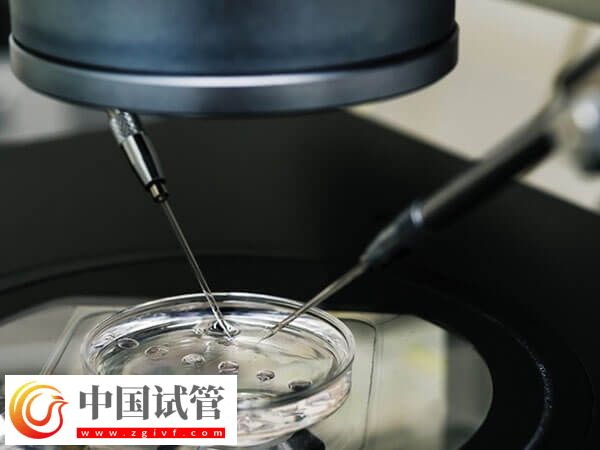
綿陽市中心醫(yī)院助孕全程開銷匯總,檢查到手術(shù)至少3w(圖1) 綿陽市中心醫(yī)院助孕全程開銷匯總,檢查到手術(shù)至少3w(圖1)

綿陽市中心醫(yī)院助孕全程開銷匯總,檢查到手術(shù)至少3w
綿陽市中心醫(yī)院成立于1939年,坐落于綿陽市繁華的城市中心,秉承“崇尚生命與科學(xué)”的價值觀,已經(jīng)成功的發(fā)展成為了一家三級甲等綜合醫(yī)院,是川西北區(qū)域醫(yī)療中心。2021年1月成為電子科技大學(xué)醫(yī)學(xué)院附屬綿陽醫(yī)院,并且在1999年的時候成為了四川省第4家可以開展輔助生殖技術(shù)的醫(yī)院,是川西北地區(qū)較早開展不孕不育診療的科室,初建時就開展了不孕不育的常規(guī)檢查及綜合治療。
綿陽市中心醫(yī)院生殖醫(yī)學(xué)中心
綿陽市中心醫(yī)院生殖醫(yī)學(xué)中心成立于1999年,位于醫(yī)院第二住院大樓12樓,占地面積逾1000平方米,由生殖婦科、男科、實驗室和護(hù)理四部分組成,現(xiàn)有醫(yī)護(hù)人員12人,其中主任醫(yī)師1名、副主任醫(yī)師2名、碩士7名,所有醫(yī)護(hù)人員均完成了衛(wèi)生部人類輔助生殖技術(shù)培訓(xùn)基地培訓(xùn),并取得相應(yīng)合格證書。
中心可以開展的技術(shù)有夫精人工授精技術(shù)、常規(guī)體外受精-胚胎移植技術(shù)、卵胞漿內(nèi)單精子顯微注射技術(shù)、睪丸穿刺取精術(shù)、附睪穿刺取精術(shù)、囊胚培養(yǎng)、胚胎輔助孵化、凍融胚胎復(fù)蘇移植技術(shù)、多胎妊娠減胎術(shù)等。
綿陽市中心醫(yī)院試管嬰兒費用明細(xì)
試管嬰兒的費用包括檢查、促排卵、取卵、移植等,且試管嬰兒分為一代、二代、三代,每一代的技術(shù)費用也是不同的,都是需要因人而異的,具體費用如下:
身體檢查
在進(jìn)行試管嬰兒前,需要進(jìn)行一系列的體檢,包括男女雙方的精液、卵子等檢查,還需要進(jìn)行全面的身體檢查,以確保身體狀況符合進(jìn)行試管嬰兒的要求,大約5000元左右。

藥品費用
試管嬰兒需要使用一系列的藥物來促進(jìn)卵子的發(fā)育和排卵,還需要使用促性腺激素等藥物來促進(jìn)卵子和精子的結(jié)合。這些藥品都是比較昂貴的,費用在1-2萬左右。
手術(shù)費用
試管嬰兒手術(shù)的費用包括卵子采集、受精卵培養(yǎng)、胚胎移植等環(huán)節(jié),另外,試管嬰兒手術(shù)后需要進(jìn)行一系列的檢查和治療,以確保胚胎的安全和健康,費用差不多10000元。
以上就是關(guān)于在綿陽市中心醫(yī)院做試管嬰兒的相關(guān)費用,大致范圍是在3-5萬元左右,不過具體的是需要因人而異的,建議結(jié)合自己的實際情況上醫(yī)院進(jìn)行評估。
綿陽市中心醫(yī)院試管成功率
試管嬰兒流程大致分為進(jìn)周促排、取卵取精、胚胎培養(yǎng)、檢測與移植,涉及到不同的階段其操作步驟會存在差異,由于本身做試管嬰兒的費用、流程、成功率無外乎是姐妹們最為關(guān)心的幾個問題,以下就給大家分享關(guān)于該醫(yī)院的成功率數(shù)據(jù):
- 1. 如果說女性的年齡在35歲以下的話,成功率是可以達(dá)到65%的;
- 2. 35-40歲之間的女性其成功率在55%左右;
- 3. 40-50歲之間的女性做試管的成功率在30%-40%左右;
- 4. 如果年齡超過50歲的女性做試管的話,其成功率會很低,可能只有10%左右。





